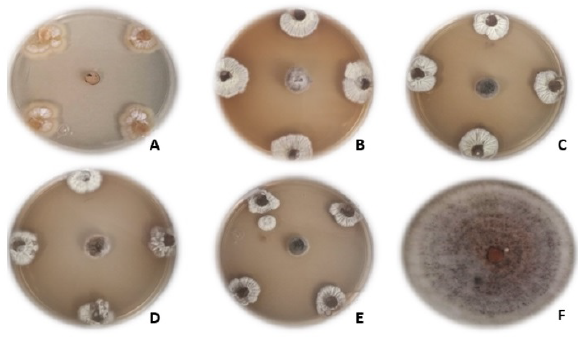

INTRODUCCIÓN
El mango (Mangifera indica L.) es uno de los principales cultivos perennes en México, considerado el tercer productor a nivel mundial, con una superficie cultivada de 202 631 ha; de las cuales la mayor producción se exporta a los Estados Unidos de América, Canadá y Japón (SIAP 2018). En el estado de Nayarit, su producción está limitada por problemas fitosanitarios, especialmente por la moscas de la fruta (Anastrepha spp.), escama blanca del mango (Aulacaspis tubercularis), cochinilla rosada del hibisco (Maconellicoccus hirsutus), fumagina (Capnodium mangiferae) y antracnosis (Colletotrichum gloeosporioides) (Isiordia et al. 2011). Siendo la antracnosis, la principal enfermedad fungosa a nivel mundial, causando pérdidas económicas en pre y postcosecha, principalmente en regiones con temperaturas y humedad relativa elevada (Prusky et al. 2000).
En México, se tiene registrada en todas las regiones productoras de mango la incidencia de atracnosis en la floración, fructificación y postcosecha, con pérdidas de entre el 30 y 60% (Allende et al. 2001). La enfermedad causa daños en hojas, flores y frutos, lo que ocasiona pérdidas importantes, dado que el inóculo infectivo se encuentra presente todo el año (Benítez et al. 2003). Los daños más severos los causa en fruto, especialmente, si la infección ocurre en la etapa inicial del desarrollo, ocasionando manchas oscuras y aborto de frutos pequeños, lo que reduce la calidad y rendimiento (Kamle y Kumar 2016). El manejo de la atracnosis se basa en un enfoque integrado que combina las medidas más eficaces en función del cultivar, la localidad de producción y el mercado final (Gutiérrez et al. 2004). Por lo que el interés en el desarrollo de métodos alternativos de control, ocasiona que se intensifiquen los esfuerzos por detectar microorganismos benéficos con potencial para ser usados como agentes de biocontrol para reducir las poblaciones de fitopatógenos, y disminuir las aplicaciones de moléculas químicas (Rodríguez-Villareal et al. 2014, García et al. 2019).
Los microorganismos benéficos son amigables con el ambiente, debido a su capacidad de sintetizar compuestos antifúngicos y enzimas degradadoras de la pared celular de hongos patógenos, mecanismos mediante los cuales inhiben el desarrollo de fitopatógenos, además de reducir la incidencia y severidad de enfermedades en agroecosistemas (Medina y Evangelista 2011). Adicionalmente, los microorganismos antagónicos crecen de forma rápida, se adaptan de forma fácil, inducen el sistema de defensa de la planta hospedera de los patógenos y contribuyen a la asimilación de nutrientes (Ezziyyani et al. 2004). Siendo los actinomicetos los productores más importantes de metabolitos secundarios con actividad biológica, donde el género Streptomyces destaca como el principal productor (Rodríguez et al. 2005). Por lo anterior, el objetivo de la investigación fue identificar actinomicetos aislados de suelo de árboles de mango en el estado de Nayarit, México y evaluar su potencial antifúngico in vitro contra Colletotrichum sp.
MATERIALES Y MÉTODOS
Ubicación del sitio experimental
Los actinomicetos, se aislaron de muestras de suelo de 500 a 600 g obtenidas a una profundidad de entre 10 y 15 cm de profundidad (rizosfera) de árboles de mango cv. Ataulfo, ubicados en los cuatro puntos cardinales y el centro de la superficie total de cinco huertos comerciales de la localidad de Sauta, municipio de Santiago Ixcuintla, Nayarit, México (Tabla 1).
Tabla 1 Sitios de recolecta de muestras de suelo en huertos de mango en la localidad de Sauta del municipio de Santiago Ixcuintla en el estado de Nayarit, México, para el aislamiento de actinomicetos.
| Huertos | Ubicación geográfica | Altitud* |
|---|---|---|
| 1 | 21o 43’42” LN | 29 |
| 105o 08’27” LO | ||
| 2 | 21o 43’20” LN | 30 |
| 105o 07’57” LO | ||
| 3 | 21o 42’40” LN | 25 |
| 105o 09’03” LO | ||
| 4 | 21o 42’40” LN | 49 |
| 105o 07’50” LO | ||
| 5 | 21o 42’58” LN | 42 |
| 105o 08’05” LO |
* metros sobre el nivel del mar.
Las muestras se trasladaron en bolsas de polietileno (Ecobolsas® 20 × 30 cm) al Laboratorio de Parasitología Agrícola de la Unidad Académica de Agricultura de la Universidad Autónoma de Nayarit donde se almacenaron a 4oC, hasta su procesamiento.
Aislamiento e identificación morfológica de actinomicetos
Las muestras de suelo de cada huerto se homogeneizaron, para luego tomar una submuestra de 10 g, que se diluyó en 90 mL de agua destilada estéril, para luego agitar de forma constante por 30 min. Posteriormente, se tomó una alícuota de 1 mL que se colocó en un tubo de ensayo con 9 mL de agua destilada estéril, a partir de esto, se realizaron diluciones seriadas, hasta obtener las diluciones 10-4, 10-5 y 10-6, de las cuales se tomaron 50 µL que se depositaron en cajas Petri de 90 mm de diámetro con medio de cultivo Agar Papa Dextrosa (PDA) o Agar Czapek Dox (CZA). Para luego incubarse a 28oC por 15 días en una cámara de crecimiento (Novatech Ei45), hasta observar crecimiento de actinomicetos. Las colonias de este microorganismo se aislaron y purificaron en PDA, e incubaron a 28oC por 15 días. Los actinomicetos se identificaron por sus características macroscópicas (Figura 1) y microscópicas bajo un microscopio compuesto Motin a 1000X de magnificaciones (Williams y Cross 1971).

Figura 1 Árbol filogenético de máxima verosimilitud basado en el gen 16S ARNr construido con el software Mega X (bootstrap = 1000), con el modelo de sustitución Tamura 3-parameter, los valores bootstrap se muestran como porcentajes. El árbol se dibujó a escala, con longitudes de rama medidas en el número de sustituciones por sitio, la barra de escala representa 1 sustitución de nucleótidos por cada 100 nucleótidos. La secuencia de Amycolatopsis umgeniensis se tomó como grupo externo.
Confrontaciones preliminares in vitro de antibiosis
Se realizaron pruebas preliminares de antibiosis de los actinomicetos contra Colletotrichum sp., para seleccionar aquellos aislados con actividad antifúngica. Para ello, se colocaron fragmentos de 0.5 cm de diámetro de cada colonia de actinomiceto en un extremo de las cajas de Petri y se incubaron a 28oC, cinco días después se colocó un fragmento de la colonia de Colletotrichum sp. a distancia aproximada de 6.5 cm de cada actinomiceto. Los actinomicetos incapaces de inhibir el crecimiento de micelio del hongo a los 10 días se descartaron.
Confrontación in vitro
Con base en los resultados preliminares se seleccionaron los actinomicetos que mostraron actividad antifúngica. Los aislados seleccionados se confrontaron in vitro contra Colletotrichum sp., proporcionado por el cepario del Laboratorio de Parasitología Agrícola de la Unidad Académica de Agricultura. Este patógeno se seleccionó debido a su incidencia en la región productora de mango, de donde se aislaron los actinomicetos. Cada antagonista se sembró de acuerdo con Pérez-Corral et al. (2015), mediante fragmentos de la colonia de 5 mm de diámetro, los cuales se colocaron en los cuatro puntos cardinales de la caja de Petri con PDA, y se incubaron a 28oC por 10 días. Para después colocar un fragmento con micelio de la colonia del fitopatógeno en el centro de la caja de Petri y se incubó de nuevo bajo las mismas condiciones. Como testigo, se sembró el hongo fitopatógeno en el centro de la caja de Petri con PDA, el crecimiento radial de la colonia de Colletotrichum sp. confrontado ante cada actinomiceto y del testigo se midió cada 24 h. El día en que el testigo lleno la caja de Petri, se registró la inhibición de los actinomicetos. La capacidad antifúngica de los aislados se determinó con base en el porcentaje de inhibición de crecimiento radial (PICR) de acuerdo con la formula PICR = (R1 - R2) / R1 × 100, donde R1 fue el radio del hongo testigo y R2 fue el radio del hongo en la confrontación con los antagonistas (Ezziyyani et al. 2004).
Para el análisis estadístico, se utilizó un diseño completamente al azar, el experimento consistió en 25 tratamientos (actinomicetos antagónicos), confrontados contra Colletotrichum sp. además del testigo Colletotrichum sp. en ausencia del antagonista. Todas las evaluaciones se realizaron por triplicado. Los datos del PICR se analizaron mediante análisis de varianza (ANDEVA) con el programa Statistical Analysis System versión 9.0 (SAS 2002), y la comparación de medias se realizó con la prueba de Tukey (p = 0.05).
Identificación molecular
Los 12 actinomicetos con los mejores valores de inhibición in vitro se les realizó la caracterización molecular. El ADN genómico (ADNg) se extrajo de acuerdo con Ruiz-Cisneros et al. (2017), con modificaciones, que consistieron en obtener un pre-cultivo en caldo ISP2 (International Streptomyces Project) a 28oC con agitación a 250 rpm por 3 días, se centrifugaron a 15 000 g por 5 min, y se desechó el sobrenadante, la pastilla resultante se resuspendió en 300 µL de amortiguador j (Trizma base - ácido clorhídrico 1 M, EDTA 0.1 M, cloruro de sodio 0.15 M, pH 8). La suspensión se centrifugó a 15 000 g por 5 min y el sedimento obtenido se suspendió en 200 µL de amortiguador j. Luego, se agregaron 12 µL de lisozima (40 mg mL-1) y la mezcla se incubó a 37oC por 30 min. Posteriormente, se agregaron 12 µL de SDS al 10% y la mezcla de reacción se incubó a 70oC por 10 min. Se agregaron 2 µl de RNasa (10 mg mL-1) y la mezcla se mantuvo a 60oC por 30 min. Para luego agregar 7 µL de proteinasa K (10 mg mL-1), manteniendo la mezcla a 37oC por 30 min. Posteriormente se agregaron 35 µL de NaCl 5 M y la mezcla de reacción se mantuvo en hielo por 15 min. para luego centrifugar la mezcla a 15 000 g por 11 min y el sobrenadante obtenido mezclarlo con isopropanol (1:1, v / v), mantener a -80oC por 20 min, y centrifugar a 15000 por 15 min. El sobrenadante se desechó agregando 200 µL de etanol al 70% y se centrifugó a 5 000 g por 10 min. El sedimento resultante se secó a temperatura ambiente por 5 min y se resuspendió en 30 µL de agua Milli-Q estéril. La calidad del ADNg se determinó mediante electroforesis en gel de agarosa al 1%. Para luego realizar la amplificación del gen 16S ARNr con los iniciadores específicos para actinomicetos con alto contenido de guanina y citosina F243 (5’ GGATGAGCCCGCGGCCTA 3’) y R1378 (5’ CGGTGTGTACAAGGCCCGGGAACG 3’), las condiciones de amplificación consistieron en las siguientes etapas: (i) desnaturalización de ADN a 94 C por 5 min, (ii) 30 ciclos, los cuales incluyen desnaturalización a 94oC por 1 min, alineamiento a 63oC por 1 min y extensión a 72oC por 2 min y (iii) una extensión final a 72 C por 10 min (Heuer et al. 1997, Duthoit et al. 2003). Los productos de PCR fueron examinados por electroforesis en gel de agarosa al 1% y se secuenciaron por la empresa Macrogen (Rockville, Maryland, EUA). Las secuencias obtenidas se compararon con las bases de datos del National Center for Biotechnology Information (NCBI) con el algoritmo de BLAST. Se construyó un árbol filogenético de máxima verosimilitud usando el modelo Tamura 3-parameter, con 1000 réplicas de Bootstrap mediante el software Mega X (Kumar et al. 2018), para lo cual se realizó un alineamiento múltiple de los datos mediante el software CLUSTAL_X.
RESULTADOS Y DISCUSIÓN
De las muestras de suelo asociado a la rizosfera de árboles de mango en zonas productoras del estado de Nayarit se obtuvieron 112 aislados de actinomicetos de acuerdo con sus características morfológicas. De la evaluación preliminar in vitro de los actinomicetos contra Colletotrichum sp., sólo 25 (22%) de los 112 mostraron algún grado de inhibición del crecimiento micelial del hongo. En los casos en los que no hubo inhibición (87 aislados), el hongo creció sobre la colonia del actinomiceto. La evaluación del PCIR de los 25 aislados sobre el crecimiento in vitro de Colletotrichum sp., se evaluó de forma cuantitativa por medio del registro diario del crecimiento de los organismos confrontados; tomando como referencia el crecimiento del hongo y del actinomiceto, con porcentaje de inhibición de 36.6 a 100.0% (Tabla 2), lo que demuestra la inhibición. Al respecto, Macedo et al. (2011) mencionan que estos experimentos in vitro permiten establecer diferencias métricas entre confrontaciones y comparar cualitativamente el antagonismo entre aislados, sin embargo, no es posible determinar el grado de variación entre colonias de los aislamientos. En la Figura 2 se muestra la inhibición del fitopatógeno causada por cinco aislados de actinomicetos (St-111, St-51, St-25, St-27 y St-52), que mostraron mayor inhibición del crecimiento con respecto al testigo, donde se observó que el crecimiento del micelio del hongo disminuyo hacia la colonia del actinomiceto, y a partir de ese momento el patógeno detuvo su crecimiento, por la actividad antifúngica de los actinomicetos.
Tabla 2 Identificación de actinomicetos y su inhibición micelial in vitro sobre Colletotrichum sp.
| Aislamiento | Cepas | GenBank | % inhibición* |
|---|---|---|---|
| St-111 | Streptomyces varsoviensis | NR043497.1 | 100.00 a |
| St-51 | Streptomyces abikoensis | NR118286.1 | 92.92 ab |
| St-25 | Streptomyces abikoensis | NR118286.1 | 92.63 ab |
| St-27 | Streptomyces abikoensis | NR118286.1 | 91.03 abc |
| St-52 | Streptomyces abikoensis | NR118286.1 | 90.56 abc |
| St-92 | Streptomyces sp. | 87.43 bcd | |
| St-46 | Streptomyces lilacinus | NR112573.1 | 84.96 bcde |
| St-03 | Streptomyces minutiscleroticus | NR112379.1 | 81.43 bcde |
| St-72 | Streptomyces minutiscleroticus | NR112379.1 | 80.86 bcde |
| St-02 | Streptomyces minutiscleroticus | NR112379.1 | 79.93 bcde |
| Ar-109 | Arthrobacter globiformis | NR112192.1 | 79.83 bcde |
| St-17 | Streptomyces minutiscleroticus | NR112379.1 | 77.96 cdef |
| St-20 | Streptomyces minutiscleroticus | NR112379.1 | 77.26 cdef |
| St-85 | Streptomyces sp. | 74.90 def | |
| St-10 | Streptomyces sp. | 74.06 def | |
| St-110 | Streptomyces sp. | 72.66 ef | |
| St-104 | Streptomyces sp. | 72.53 ef | |
| St-81 | Streptomyces sp. | 65.40k | |
| St-99 | Streptomyces sp. | 48.83 g | |
| St-75 | Streptomyces sp. | 48.56 g | |
| St-59 | Streptomyces sp. | 48.40 g | |
| St-107 | Streptomyces sp. | 46.33 g | |
| St-64 | Streptomyces sp. | 46.13 g | |
| St-55 | Streptomyces sp. | 39.83 g | |
| St-50 | Streptomyces sp. | 36.66 g | |
| Testigo 00.00 |
* Medias con la misma letra, son estadísticamente iguales de acuerdo con Tukey (p = 0.05).
Figura 2 Inhibición del crecimiento de Colletotrichum sp. al confrontarse con los aislados de actinomicetos St-111 (A), St-51 (B), St-25 (C), St-27 (D) y St-52 (E), con respecto al testigo (F).
Los iniciadores específicos, amplificaron un fragmento de ARNr 16S de aproximadamente 1100 pb a partir de los 12 aislados sobresalientes. Las secuencias obtenidas se depositaron en el NCBI del GenBank (Tabla 2). Mediante el análisis BLAST se encontró que las secuencias de los diversos aislamientos presentaron alta identidad (99%), con las secuencias reportadas en el NCBI para el género Streptomyces (91.66%), mientras que un aislado (8.33%) mostró estar relacionado con el género Arthobacter. Para establecer con más precisión la posible identidad, a nivel de especie de los actinomicetos caracterizados, secuencias de diversas especies de Streptomyces, homologas en un 99% a las secuencias obtenidas, se alinearon y agruparon mediante un análisis filogenético generando el árbol filogenético (Figura 1).
En las pruebas preliminares de antibiosis, 25 aislados (23.3%) mostraron actividad antagónica in vitro por 15 días contra Colletotrichum sp., lo que demuestra el elevado número de actinomicetos antagónicos a este fitopatógeno. La falta de actividad antagónica en la mayoría de los aislados posiblemente se debe a diversos mecanismos de defensa que el hongo patógeno pudiera poseer a los compuestos producidos por los actinomicetos (Duffy et al. 2003). La ocurrencia de antagonismo in vitro con inhibiciones del 36.6 al 100.0% sugiere la producción de compuestos inhibitorios distintos entre los aislados de actinomicetos, tomando en cuenta que se han reportado cerca de 10 100 de compuestos bioactivos producidos por actinomicetos (Berdy 2005). Sobre lo mismo Ezziyyani et al. (2004) y Evangelista-Martínez (2014) mencionan que aislados de actinomicetos del género Streptomyces, son capaces de inhibir el crecimiento in vitro de diferentes géneros de hongos fitopatógenos, como se ha observado en Colletotrichum spp (El-Tarabily 2006, Gopalakrishnan et al. 2011). Al respecto, Svetlana et al. (2010) reportan a Streptomyces noursei causando inhibiciones superiores al 80% sobre C. acutatum y C. gloeosporioides. En contraste Macedo et al. (2011), registraron bacterias de los géneros Bacillus y Burkholderia con inhibiciones del 43.2 al 56.7% sobre C. gloeosporioides.
El aislado de Streptomyces varsoviensis identificado, causó el 100% de inhibición de Colletotrichum, al respecto se tienen reportes que esta especie produce higrobafilomicina (Ndejouong et al. 2010), potente compuesto antifúngico que puede estar relacionado con la respuesta. Los cuatro aislados identificados como S. abikoensis y los cinco de S. minutiscleroticus inhibieron a Colletotrichum en un rango del 90.56 al 92.92% y del 77.26 al 81.43%, respectivamente; lo que demuestra relación entre aislados de cada especie. Se desconocen investigaciones previas en las que S. varsoviensis, S. abikoensis, S. minutiscleroticus, S. lilacinum y A. globiformis se reporten como antagónicas a alguna especie de Colletotrichum spp. Los porcentajes de inhibición der estas especies son elevados y abren la posibilidad para evaluarse contra diversos hongos fitopatógenos, como lo reporta Evangelista-Martínez (2014). Actualmente, los compuestos bioactivos (antibióticos) de actinomicetos pueden ser aislados y purificados por métodos químicos y para producirlos a nivel industrial (Al-Askar et al. 2011, Dávila-Medina et al. 2013, Xue et al. 2013), por lo que es necesario realizar estudios del potencial antifúngico de S. varsoviensis.
Los resultados indican diversidad de actinomicetos nativos de la rizosfera del suelo de árboles de mango de Santiago Ixcuintla, Nayarit, además de capacidad antagónica in vitro contra Colletotrichum sp. Para más del 22% de los actinomicetos aislados. Se observó actividad antagónica a Colletotrichum sp. de S. varsoviensis, S. abikoensis, S. minutiscleroticus, S. lilacinum y A. globiformis con, por lo que, podrían usarse como agentes de biocontrol de especies y cepas de este y otros géneros de hongos patógenos.










nueva página del texto (beta)



